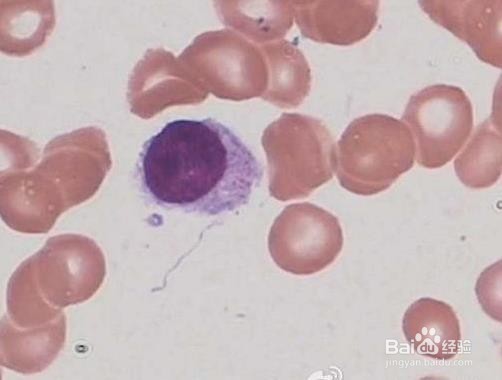
怎样辨认骨髓片子？这是哪种细胞啊？
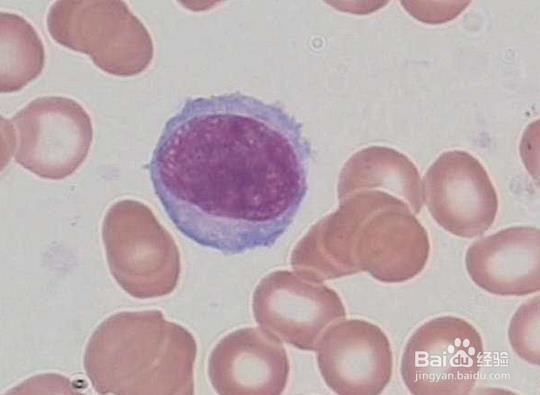
怎样辨认骨髓片子？这是哪种细胞啊？

怎样辨认骨髓片子?这是哪种细胞啊?
1、红细胞系统最早阶段。胞体是比较大的,细胞核的颜色是紫红色的,细胞质的颜色是墨蓝色的,核、染色质沙粒状,核仁1~2个。
2、虽说原红细胞和早幼红细胞很是相近,不易分清,但是一般尾足明显的红细胞,是原红细胞。
3、这里原红细胞和早幼红最大的一个区分点是:有核仁。有核仁的红细胞是原红,而没有的为早幼红。

1、仔细看的话,早幼红其实和原红并没有太大的区别。胞质多了点,染色质粗了点,胞质颜色变淡了点,这些都不易察觉。
2、早幼红细胞就是原红细胞成熟的一个阶段,最大的区别还是在于核仁,这是区分二者的最有力武器。

1、更加成熟了,细胞浆紫红色,核、染色质块状结构,核浆比例几乎1:1。
2、因为血红蛋白开始合成,呈不同程度的嗜多色性,核染色质聚集成深红索条状,副染色质明显。

1、晚幼红细胞阶段,胞质接近成熟红,核染色质聚集成紫黑色团块。

1、红细胞和粒细胞最大的区别在于没有颗粒。红细胞各阶段都没有颗粒。这是区别红细胞和粒细胞的一大法宝。

2、只有原红细胞阶段有核仁。
3、中幼红细胞阶段核浆比例大约在1:1。

4、随着细胞的成熟,胞体是变小的,核染色质是变得更加致密,进一步就是浓缩成块,核仁是逐渐模糊直到消失。
声明:本网站引用、摘录或转载内容仅供网站访问者交流或参考,不代表本站立场,如存在版权或非法内容,请联系站长删除,联系邮箱:site.kefu@qq.com。
阅读量:40
阅读量:150
阅读量:180
阅读量:166
阅读量:196